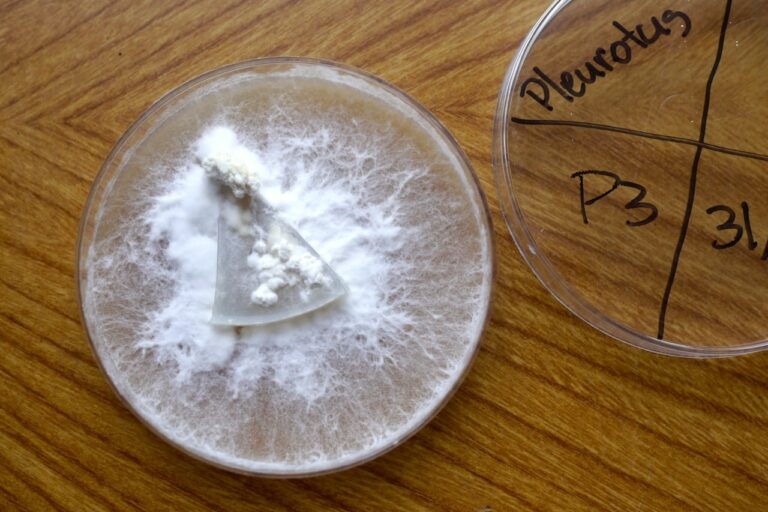

View allAnimalsAppropriate TechnologyAquaponicsBook RecommendationsChickens & QuailsCommunity Projects & ResilienceComposting & Nutrient CyclingCourses & WorkshopsDucksFermenting, Pickling & PreservingForagingForest Gardening & SilvicultureFree GuidesGoatsHabits for HopeInsects & PollinatorsLife at MelliodoraLife at Milkwood FarmLife at Quoll HollowMarket GardeningMilkwood Permaculture Living HandbookMushroom CultivationMushroom ForagingNatural BeekeepingNatural BuildingOrganic GardeningPermaculturePermaculture DesignPermaculture FuturesPermaculture LivingPermaculture Living studentsPermaculture RentingPigsRadical HopeRambling & AdventuresRecipesRegenerative FarmingSchool GardeningSeaweedSeed SavingStudent PDC DesignsStudent StoriesThe Milkwood bookTomatoesUrban PermacultureVegetable GardeningWater Harvesting & ReuseWorm Farming